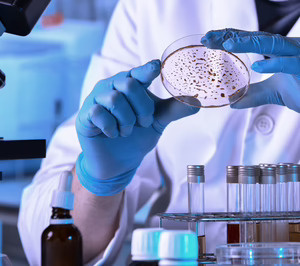
Grupo Proquimia: nuevas inversiones y crecimiento a dos dígitos en 2023

Construir un nuevo almacén de producto acabado es, junto a otros conceptos, uno de los principales proyectos anunciados por Grupo Proquimia para 2024. Del primero, nuestra cabecera Alimarket Logística publicaba recientemente algunos de sus detalles más relevantes. Pero nos preguntamos: ¿qué otros planes tiene en cartera esta fabricante de Vic (Barcelona) especializada en limpieza e higiene industrial? Esta noticia hace referencia a las inversiones más recientes y previstas de este operador que figura entre los principales del sector, tal como recoge el Informe 2023 de Limpieza e Higiene Profesional en España. E incluye un gráfico con la evolución de sus principales magnitudes económicas en los últimos años.